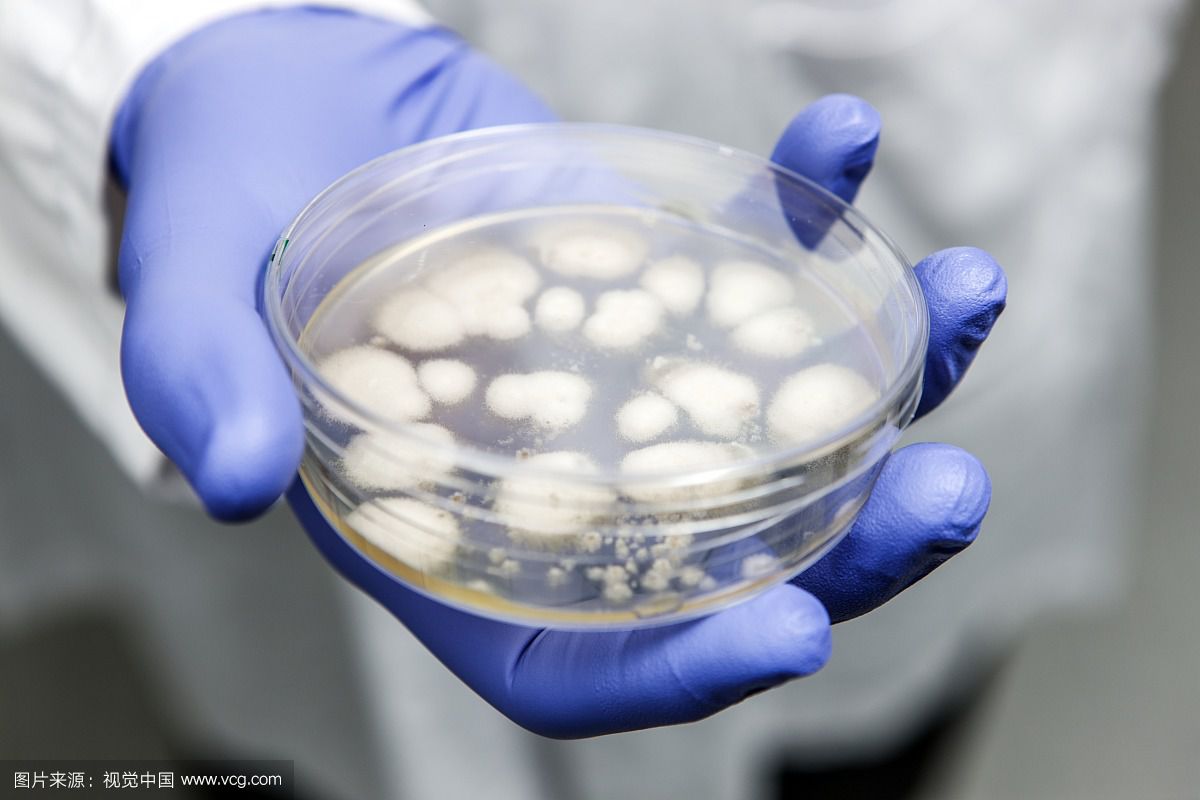
对人类贡献最大的药,青霉素的历史影响

人类历史上最伟大的药物是什么我不知道,但要说对人类历史进程影响力最大的十种药物的话,则必须有青霉素的一席之地。
青霉素(Penicillin,或音译盘尼西林),霉素是抗菌素的一种,是指分子中含有青霉烷、能破坏细菌的细胞壁并在细菌细胞的繁殖期起杀菌作用的一类抗生素,是由青霉菌中提炼出的抗生素。
青霉素的出现,使人类找到了一种具有强大杀菌作用的药物,结束了传染病几乎无法治疗的时代;从此出现了寻找抗菌素新药的高潮,人类进入了合成新药的新时代。

英国细菌学家,生物化学家,微生物学家亚历山大·弗莱明(1881年8月6日—1955年3月11日)于1923年发现溶菌酶,1928年首先发现了青霉素。后英国病理学家弗洛里、德国生物化学家钱恩进一步研究改进,并成功的用于医治人的疾病。

一方面有了这些研究成果,一方面第二次世界大战正在展开,急需一种药物来治疗士兵的伤口感染。在多方力量的推动下,美国制药企业首先于1942年开始对青霉素进行大批量生产。这种新的药物对控制伤口感染非常有效。
1943年10月,英国牛津大学病理学家霍华德·弗洛里和美国军方签订了首批青霉素生产合同。青霉素在二战末期横空出世,迅速扭转了盟国的战局。战后,青霉素更得到了广泛应用,拯救了数以千万人的生命。到1944年,药物的供应已经足够治疗第二次世界大战期间所有参战的盟军士兵。
战后,青霉素更得到了广泛应用,拯救了数以千万人的生命。因这项伟大发明,1945年,弗莱明、弗洛里和钱恩因“发现青霉素及其临床效用”而共同荣获了诺贝尔生理学或医学奖。
我是头条号:以史为鉴,埋没的历史真相、误解的历史人物、不为外人所知的关系……我来为您讲述,欢迎关注。